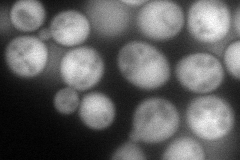
YPL051W
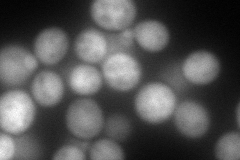
YPL051W
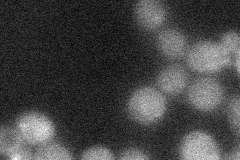
YPL051W
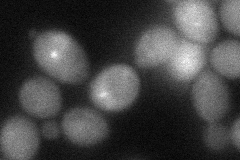
YPL051W

Localization:
Intensity:
Fold change:
Significance:
-
C’ GFP library in SD

0 -
N' NOP1pr-GFP in SD
cytosol108.371 -
N' TEF2pr-mCherry in SD
cytosol179.739 -
N' NATIVEpr-GFP in SD
cytosol21.5858 -
N' TEF2pr-VC and Cyto-VN in SD
cytosol43.5118 -
C’ GFP library in SD+DTT

N/A0N/AYes -
C’ GFP library in SD+H2O2

N/A0N/AYes -
C’ GFP library in Starvation Media

N/A0N/AYes -
C’ GFP library on the background of Pup2-DaMP

N/A -
C’ GFP library on the background of CCT mutant

N/A0N/AYes
